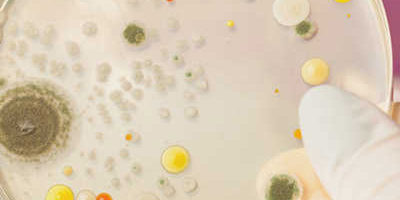
Erneuerung unserer Hygienezertifizierung

Eine Luftbefeuchtungsanlage muss dem Stand der Technik entsprechen. Hierzu gehört die Überprüfung einer unabhängigen Einrichtung, die mit ihren Spezialisten rund um das Thema “hygienische Luftbefeuchtung” immer auf dem aktuellsten wissensstand Stand sind.
Viele Prüfinstitute mit unterschiedlichen Prüfkriterien. Wir haben uns für den TÜV entschieden, da uns dort die Anforderungen am schärfsten erschienen und unsere Kunden mit dem Name auch höchste Qualität verbinden.
Der TÜV Industrieservice kann sogar DVGW und Trinkwasser-Zertifiziuerungen ablehnen, wenn Diese nicht von speziellen Instituten erstellt wurden.
Natürlich ist die Zulassung ein wesentliches Thema – zu dem natürlich noch die halbjährliche Wartung nach DIN 6022 hinzukommt.
Sprechen Sie uns einfach an, um nähere Infos zu erhalten!